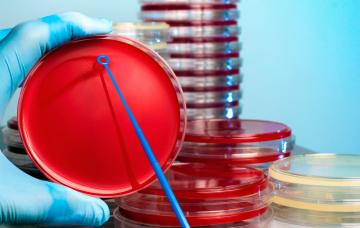
Diagnóstico de la salmonelosis en un hemocultivo

Salmonelosis

Por: Dr. José Antonio Nuevo González
Especialista en Medicina Interna. Servicio de Urgencias del Hospital Gregorio Marañón de Madrid
- 1

Qué es la salmonelosis y por qué se produce
La salmonelosis es una infección intestinal muy frecuente, que se transmite por la ingesta de alimentos contaminados con una bacteria denominada Salmonella.
Leer más - 2

Síntomas de salmonelosis
Entre los síntomas de la infección por Salmonella están diarrea, dolor abdominal y fiebre, aunque suelen ir acompañados de náuseas, vómitos y dolor muscular.
Leer más - 3

Diagnóstico de la salmonelosis
Conoce qué procedimientos se emplean para diagnosticar la salmonelosis mediante la identificación de la Salmonella, la bacteria causante de esta intoxicación.
Leer más - 4

Tratamiento de la salmonelosis
El tratamiento de la infección por salmonella suele basarse en la reposición de líquidos y una alimentación suave. Conoce cuándo se recurre a antibióticos.
Leer más - 5

Alimentación durante la salmonelosis
Durante la fase aguda de la salmonelosis (con diarrea y fiebre) es fundamental reponer los líquidos perdidos y el consumo de alimentos astringentes.
Leer más - 6

Cómo prevenir la salmonelosis
La clave para evitar la salmonela es extremar las medidas higiénicas cuando manipulamos los alimentos (sobre todo el huevo, carnes o pescados crudos).
Leer más